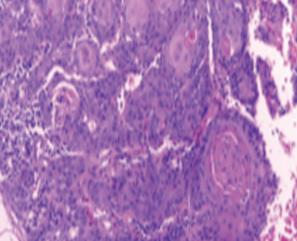

Carcinoma oral de células escamosas en pacientes jóvenes
DOI:
https://doi.org/10.35954/SM2021.40.1.4Palabras clave:
Carcinoma de Células Escamosas; Carcinoma de Células Escamosas de Cabeza y Cuello; Neoplasias de Cabeza y Cuello; Neoplasias de la Boca; OdontologíaResumen
El carcinoma oral de células escamosas es la neoplasia maligna más frecuente de la cavidad oral, presentándose fundamentalmente en personas mayores de 60 años, aunque recientemente se ha observado un aumento de su incidencia en individuos jóvenes.
La etiología del carcinoma oral de células escamosas en pacientes jóvenes aún no está esclarecida, destacándose en la literatura que los factores de riesgo clásicos como el tabaco, el alcohol y la infección por el virus del Papiloma Humano, no tendrían implicancia en su etiopatogenia; siendo el microambiente tumoral la principal diferencia biológica observada entre los distintos grupos etarios.
Históricamente se consideró que el carcinoma oral de células escamosas en personas jóvenes era más agresivo, sin embargo, estudios actuales han demostrado que no existen diferencias significativas con respecto al desarrollado por personas de edad más avanzada, resaltando que el pronóstico y el plan de tratamiento no deben ser definidos en función de la edad cronológica al momento del diagnóstico, sino por el estadio de la enfermedad.
En el presente trabajo se realiza una revisión de la literatura con la finalidad de actualizar el conocimiento acerca del carcinoma oral de células escamosas en pacientes jóvenes, resaltando la importancia de que todo profesional de la salud que actúa en la cavidad oral lo tenga presente, examinando en forma rutinaria los tejidos blandos y ante toda lesión sospechosa de malignidad, independientemente de la edad y de la asociación o no de factores de riesgo, realice la derivación oportuna.
Recibido para evaluación: Octubre 2020.
Aceptado para publicación: Febrero 2021.
Correspondencia: General las Heras 1925. C.P.11600. Montevideo, Uruguay. Tel.: (+598) 2487 3048.
Email de contacto: hnmondon@montevideo.com.uy
Descargas
Citas
(1) Gamez ME, Kraus R, Hinni ML, Moore EJ, Ma DJ, Ko SJ, et al. Treatment outcomes of squamous cell carcinoma of the oral cavity in young adults. Oral Oncol [Internet]. 2018;87(August):43-48. Available from: https://doi.org/10.1016/j.oraloncology.2018.10.014 [Consulted 15/08/2020]
(2) de Morais EF, Mafra RP, Gonzaga AKG, de Souza DLB, Pinto LP, da Silveira ÉJD. Prognostic Factors of Oral Squamous Cell Carcinoma in Young Patients: A Systematic Review. J Oral Maxillofac Surg [Internet]. 2017;75(7):1555-1566. Available from: http://dx.doi.org/10.1016/j.joms.2016.12.017 [Consulted 15/08/2020]
(3) Villanueva FG, Leyva ER, Gaitan LA. Cáncer en pacientes Jóvenes (Parte 1): Análisis clínico e histopatológico de carcinoma de células escamosas de la cavidad bucal en pacientes jóvenes. Un estudio descriptivo y comparativo en México. Odontoestomatología [Internet]. 2016 Mayo [citado 2020 Ago 14] ; 18(27):44-48. Disponible en: http://www.scielo.edu.uy/scielo.php?script=sci_arttext&pid=S1688-93392016000100006&lng=es.
(4) Santos HB, dos Santos TK, Paz AR, Cavalcanti YW, Nonaka CF, Godoy GP, et al. Clinical findings and risk factors to oral squamous cell carcinoma in young patients: A 12-year retrospective analysis. Med Oral Patol Oral Cir Bucal 2016; 21(2):e151-6. doi: 10.4317/medoral.20770
(5) Nasser H, St. John MA. The promise of immunotherapy in the treatment of young adults with oral tongue cancer. Laryngoscope Investig Otolaryngol 2020;5(2):235-42. doi: 10.1002/lio2.366
(6) Costa V, Kowalski LP, Coutinho-Camillo CM, Begnami MD, Calsavara VF, Neves JI, et al. EGFR amplification and expression in oral squamous cell carcinoma in young adults. Int J Oral Maxillofac Surg 2018; 47(7):817-823. doi: 10.1016/j.ijom.2018.01.002
(7) Jardim JF, Gondak R, Galvis MM, Pinto CA, Kowalski L. A decreased peritumoral CD1a+ cell number predicts a worse prognosis in oral squamous cell carcinoma. Histopathology 2018; 72(6):905-13. doi: 10.1111/his.13415.
(8) Toscano de Brito R, França Perazzo M, Santos Peixoto T, Weege-Nonaka C, de Melo Brito E, Granville-Garcia A. Profile of patients and factors related to the clinical staging of oral squamous cell carcinoma. Rev. salud pública [Internet]. 2018 Apr [cited 2020 Sep 14] ; 20( 2 ): 221-225. Available from: http://www.scielo.org.co/scielo.php?script=sci_arttext&pid=S0124-00642018000200221&lng=en. http://dx.doi.org/10.15446/rsap.v20n2.49508.
(9) Yosefof E, Hilly O, Stern S, Bachar G, Shpitzer T, Mizrachi A. Squamous cell carcinoma of the oral tongue: Distinct epidemiological profile disease. Head Neck 2020; 42(9):2316-2320. doi: 10.1002/hed.26177
(10) Komolmalai N, Chuachamsai S, Tantiwipawin S, Dejsuvan S, Buhngamongkol P, Wongvised C, et al. Ten-year analysis of oral cancer focusing on young people in Northern Thailand. J Oral Sci 2015; 57(4):327-34. doi: 10.2334/josnusd.57.327
(11) Oreamuno Y V. Carcinoma oral de células escamosas diagnosticado precozmente: Reporte de caso y revisión de literatura. Odovtos [Internet]. 2017 Apr [citado 2020 Sep 14]; 19( 1 ): 43-50. Disponible en: http://www.scielo.sa.cr/scielo.php?script=sci_arttext&pid=S2215-34112017000100043&lng=en. http://dx.doi.org/10.15517/ijds.v0i0.28074
(12) Ganesh D, Sreenivasan P, Ohman J, Wallström M, Braz-Silva PH, Giglio D, et al. Potentially malignant oral disorders and cancer transformation. Anticancer Res 2018; 38(6):3223-3229. doi:10.21873/anticanres.12587
(13) Mccormick NJ, Thomson PJ, Carrozzo M. The Clinical Presentation of Oral Potentially Malignant Disorders. Prim Dent J 2016; 5(1):52-63. doi: 10.1177/205016841600500106
(14) Satgunaseelan L, Allanson BM, Asher R, Reddy R, Low HT, Veness M, et al. The incidence of squamous cell carcinoma of the oral tongue is rising in young non-smoking women: An international multi-institutional analysis. Oral Oncol 2020;110:104875. https://doi.org/10.1016/j.oraloncology.2020.104875
(15) Blanchard P, Belkhir F, Temam S, El Khoury C, De Felice F, Casiraghi O, et al. Outcomes and prognostic factors for squamous cell carcinoma of the oral tongue in young adults: a single-institution case-matched analysis. Eur Arch Otorhinolaryngol 2017; 274(3):1683-1690. doi: 10.1007/s00405-016-4419-1
(16) dos Santos Costa SF, Brennan PA, Gomez RS, Fregnani ER, Santos-Silva AR, Martins MD, et al. Molecular basis of oral squamous cell carcinoma in young patients: is it any different from older patients? J Oral Pathol Med 2018; 47(6):541-6. doi: 10.1111/jop.12642
(17) Emerick C, Magalhães TG, Barki MC, Crescencio LR, Tucci R, Barros EM, et al. Perfil sociodemográfico e clinicopatológico de 80 casos de carcinoma de células escamosas de boca. J Bras Patol e Med Lab 2020; 56(1):1-6. https://doi.org/10.5935/1676-2444.20200001
(18) Maroun CA, Zhu G, Fakhry C, Gourin CG, Seiwert TY, Vosler PS, et al. An Immunogenomic Investigation of Oral Cavity Squamous Cell Carcinoma in Patients Aged 45 Years and Younger. Laryngoscope 2020; 1-8. doi: 10.1002/lary.28674
(19) Hanna GJ, Woo SB, Li YY, Barletta JA, Hammerman PS, Lorch JH. Tumor PD-L1 expression is associated with improved survival and lower recurrence risk in young women with oral cavity squamous cell carcinoma. Int J Oral Maxillofac Surg 2018; 47(5):568-577. doi: 10.1016/j.ijom.2017.09.006
(20) Fan Y, Zheng L, Mao MH, Huang MW, Liu SM, Zhang J, et al. Survival analysis of oral squamous cell carcinoma in a subgroup of young patients. Asian Pac J Cancer Prev 2014; 15(20):8887-8891. doi: 10.7314/apjcp.2014.15.20.8887
(21) Mahmood N, Hanif M, Ahmed A, Jamal Q, Saqib M, Khan A. Impact of age at diagnosis on clinicopathological outcomes of oral squamous cell carcinoma patients. Pak J Med Sci 2018; 34(3):595-599. doi: 10.12669/pjms.343.14086
(22) Chandrasekharappa SC, Chinn SB, Donovan FX, Chowdhury NI, Kamat A, Adeyemo AA, et al. Assessing the spectrum of germline variation in Fanconi anemia genes among patients with head and neck carcinoma before age 50. Cancer 2017; 123(20):3943-3954. doi: 10.1002/cncr.30802
(23) Pavani N, Srinivas P, Kothia NR, Chandu VC. Recent Advances in the Early Diagnosis of Oral Cancer : A Systematic Review. Int J Medical Rev 2017; 4(4):119-125. doi: 10.29252/IJMR-040406
(24) Netto Soares JR, Dias FL, Monteiro de Araujo Lima RR, Toscano UB, Pastl Pontes AC, Botinelly RD, et al. Assessment of quality of life in patients with advanced oral cancer who underwent mandibulectomy with or without bone reconstruction. Rev Assoc Med Bras 2018; 64(8):710-6. https://doi.org/10.1590/1806-9282.64.08.710
Publicado
Cómo citar
Número
Sección
Licencia
Derechos de autor 2021 Hugo Néstor Mondón Alvarez y Natalia Fernanda Tancredi Cueto. Los autores conservan sus derechos de autor y ceden a la revista el derecho de primera publicación de su obra, el cual estará simultáneamente sujeto a la licencia Creative Commons Reconocimiento 4.0 Internacional License que permite compartir la obra siempre que se indique la publicación inicial en esta revista.

Esta obra está bajo una licencia internacional Creative Commons Atribución-NoComercial 4.0.
Hasta 2024 utilizamos la licencia Creative Commons Atribución/Reconocimiento-NoComercial 4.0 Internacional https://creativecommons.org/licenses/by-nc/4.0/deed.es. La cual dice que: usted es libre compartir, copiar y redistribuir el material en cualquier medio o formato, también de adaptar, remezclar, transformar y construir a partir del material. Bajo los siguientes términos:
- Atribución: usted debe dar crédito de manera adecuada , brindar un enlace a la licencia, e indicar si se han realizado cambios . Puede hacerlo en cualquier forma razonable, pero no de forma tal que sugiera que usted o su uso tienen el apoyo de la licenciante.
- NoComercial: usted no puede hacer uso del material con propósitos comerciales .
A partir de 2025 los autores conservan sus derechos de autor y ceden a la revista el derecho de primera publicación de su obra, el cual estará simultáneamente sujeto a la licencia https://creativecommons.org/licenses/by-nc-sa/4.0/deed.es que permite compartir, copiar y redistribuir el material en cualquier medio o formato siempre que se indique la publicación inicial en esta revista. Adaptar, remezclar, transformar y construir a partir del material. Si remezcla, transforma o crea a partir del material, debe distribuir su contribución bajo la la misma licencia del original y no puede hacer uso del material con propósitos comerciales.
Bajo los siguientes términos:
1. Atribución: usted debe dar crédito de manera adecuada, brindar un enlace a la licencia, e indicar si se han realizado cambios. Puede hacerlo en cualquier forma razonable, pero no de forma tal que sugiera que usted o su uso tienen el apoyo de la licenciante.
2. NoComercial: usted no puede hacer uso del material con propósitos comerciales.
3. CompartirIgual: si remezcla, transforma o crea a partir del material, debe distribuir su contribución bajo la la misma licencia del original.
PlumX Metrics













































